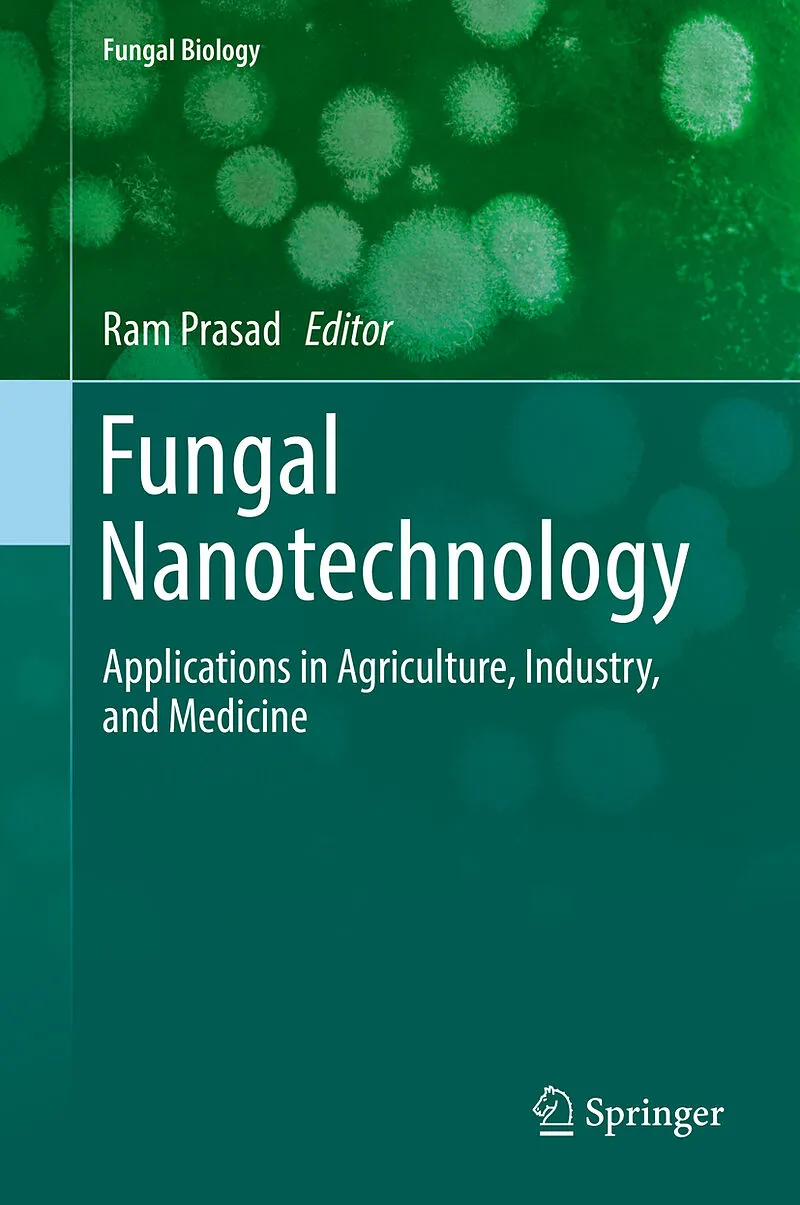

Beschreibung
Presents the potential of fungal nanotechnology in developing new products Includes its wide-range of applications to biomedicine, agriculture, and the environment Features contributions from scientists across the globe Presents the potential of fungal nanotec...Presents the potential of fungal nanotechnology in developing new products
Includes its wide-range of applications to biomedicine, agriculture, and the environment
Features contributions from scientists across the globe
Presents the potential of fungal nanotechnology in developing new products Includes its wide-range of applications to biomedicine, agriculture, and the environment Features contributions from scientists across the globe
Autorentext
Ram Prasad is Assistant Professor at the Amity Institute of Microbial Technology, Amity University, Uttar Pradesh, India. Dr. Prasad completed his Ph.D. at the Department of Microbiology, Chaudhary Charan Singh University, Meerut, UP, India, in collaboration with the School of Life Sciences, Jawaharlal Nehru University (JNU), New Delhi, India. He received his M.Sc. in Life Sciences at JNU and also qualified CSIR-NET, ASRB-NET, and GATE. His research interests include plant microbe-interactions, sustainable agriculture, and microbial nanobiotechnology. Dr. Prasad has more than hundred publications to his credit, including research papers and book chapters, five patents issued or pending, and has edited or authored several books. Dr. Prasad has eleven years of teaching experience and he has been awarded the Young Scientist Award (2007) and Prof. J.S. Datta Munshi Gold Medal (2009) by the International Society for Ecological Communications; FSAB fellowship (2010) by the Society for Applied Biotechnology; Outstanding Scientist Award (2015) in the field of Microbiology by Venus International Foundation and the American Cancer Society UICC International Fellowship for Beginning Investigators (USA 2014). In 2014-2015, Dr. Prasad served as Visiting Assistant Professor in the Department of Mechanical Engineering at Johns Hopkins University, USA.
Zusammenfassung
Presents the potential of fungal nanotechnology in developing new products
Includes its wide-range of applications to biomedicine, agriculture, and the environment
Features contributions from scientists across the globe
Inhalt
Fungal Nanotechnology: A Pandora to Agricultural Science and Engineering.- Agriculture Applications of Entomopathogenic Fungi using Nanotechnology.- Fungi as Ecosynthesizers for Nanoparticles and Their Application in Agriculture.- Myconanotechnology in Agriculture.- Fungus-mediated Bioleaching of Metallic Nanoparticles from Agro Industrial By-products.- Synthesis and Applications of Nano-Fungicides: A Next Generation Fungicide.- Enzymes and Nanoparticles Produced by Microorganisms and Their Applications in Biotechnology.- Biological Nanoparticles: Optical and Photothermal Properties.- Biogenic Synthesis of Silver Nanoparticles and Their Applications.- Fungal Bionanotechnology, when knowledge Merge into a New Discipline to Combat Antimicrobial Resistance.- Fungal Nanotechnology and Biomedicine.- Myconanotechnology to Treat Infectious Diseases: A Perspective.- Nanobiotechnology Applications in Special Reference to Fungi.
Tief- preis
